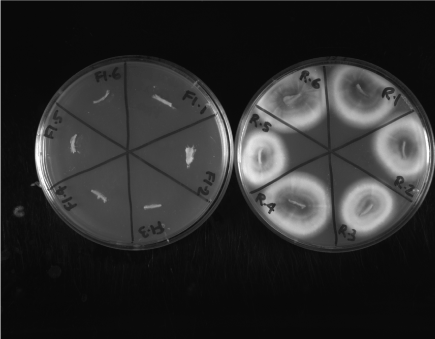

Onychomycosis is a significant medical problem, afflicting over 5% of the global human population. Current therapies are inadequate and developing effective treatments requires a suitable apparatus to allow in vitro testing of nail permeation and antifungal activities of drugs. Here we describe such an apparatus and method. Our analyses using this method showed that a novel topical drug BioCepta PM effectively penetrated human nails and killed the most common agent of onychomycosis, Trichophyton rubrum.
Onychomycosis, Nail-well, Drug Permeation and Killing, BioCepta PM
Nail infection (onychomycosis) affects people worldwide, with estimated prevalence of about 14% in North America [1], 20% in East Asia [2], and 23% [3] in Europe. Among these, about 50% are caused by fungal pathogens [4]. Epidemiological surveys have identified several risk factors for onychomycosis, including old age; compromised immunity from HIV infection, organ transplantation, and cancer treatments; wearing non-breathable tight footwear for extended periods of time; working in certain occupations such as mining, lodging, and the military; extended use of damp spaces such as locker rooms and gymnasiums that are shared by large groups of people; and physical activities such as long-distance running and playing racket sports that cause trauma to nails [4-7]. With an increasing number of people exposed to these risk factors, the prevalence of onychomycosis is expected to rise, especially in developed countries with a looming aging population. While typically not life-threatening and often dismissed as merely an unsightly nuisance, onychomycosis can cause noticeable disfigurement of the nail, discomfort, and pain, and impact mobility and occupation choices [4,8]. In severe cases, onychomycosis can lead to systemic infection, limb amputation, and even death. However, none of the current treatments are ideal and often require extended long-term therapy and/or have significant side effects, especially for oral medications [5,8]. As a result, there is a pressing need to develop effective, topical treatment strategies.
In order to develop effective topical treatments for onychomycosis, researchers must find active compounds and carriers capable of penetrating the nail and killing the infectious agents within the nail plate and underneath the plate in the nail matrix. Crucial to their success is an adequate method for assessing nail penetration by candidate drugs in vitro. However, the human nail plate is a thick, hard, keratinized structure with a curved surface [9]. As such, the nail is an effective barrier against most substances, including most current drugs. For effective in vitro testing of drug permeation, a reliable device is required to isolate the dorsal side of the nail from the ventral side, such that a drug formulation applied to the dorsal side can only reach the ventral side by permeating through the nail, not by running off the dorsal surface to the edge and seeping underneath the nail.
MedPharm’s ChubTur® and TurChub® cells purport to be such devices (3, http://www.medpharm.co.uk). Unfortunately, the ChubTur® and TurChub® cells are proprietary and not available for purchase. As a result, we have not been able to test them. We have, however, tested a device similar to theirs, the Franz Diffusion cell with a nail adapter (www.permegear.com). While the Franz Diffusion cell has been used to test for permeability of drugs [e.g. 10], it has not been used to test fungal killing across nails. In the Franz cell, the nail adapter holds a nail disc between two purpose-cut blocks of glass, with access to a 5-mm-diameter circular area of the nail disc from funnel-shaped indentations above and below the adapter. The adapter is screwed shut and clamped between an open-ended lid on top and a double chamber with various inlets and outlets below. However, with this device, we were unable to establish and confirm a controlled infection of the nail effectively when the nail was inside the adaptor. In addition, the position of the nail inside the opaque adapter prohibited the observation and measurement of the inhibitory/ fungicidal effect of the drugs. Furthermore, the cost of a single Franz Diffusion cell apparatus with a nail adapter is very high, ~$6000 each. Such a price makes the cost of running simultaneous replicates of multiple treatments for extended periods of time extremely expensive.
The lack of an appropriate device led us to design an inexpensive and efficient method for testing drug permeation and pathogen-killing activities through nails. Below we describe the successful design, the “nail-well” and show that a novel antifungal drug, BioCepta PM can effectively permeate the human nail and kill cells of the main agent of onychomycosis, Trichophyton rubrum, throughout the nail.
Human great-toenails from frozen cadavers were obtained from ScienceCare (Aurora, CO, USA). The nails were cleaned of nail-bed material and skin, and lightly sanded by hand on the dorsal side using 180-grit sandpaper. Discs of 8 mm in diameter were cut using a Boehm hollow punch (Lee Valley Tools Ltd. Ottawa, ON, Canada) and rubber mallet. The nail discs were then surface-sterilized by exposure to UV irradiation at 30 cm distance from the light source for 5 minutes for each side of the nail in a level II biosafety cabinet. The sterilized discs were placed in a heat-shrink tube (Digi-Key; Thief River Falls, MN, USA) with the nail disc at one end and the ventral side facing outward. Heat was applied using a MasterCraft 12.5A heat gun on the 250oC setting for approximately 6 seconds to shrink the tube evenly around the nail disc (Figure 1A). Excess tubing along the ventral edge of the nail disc was trimmed off. The nail-well was tested for leakage by pipetting 200 µl of sterile ddH2O into the well. Nail-wells with no leakage within one hour were considered tight. Because storage could affect the structure of the nail-well, potentially causing leakage, nail-wells were leak-tested again shortly before they were to be used. In this study, the nail-wells are used in the following two types of experiments.
Impact of drug applied on dorsal side of the nail on the growth of fungi on the ventral side of the nail
In this test, nail-wells were used to determine the permeation of a drug through the nail-well into agar by testing the effect of permeated drug on the growth of T. rubrum strain ATCC18759 that was embedded in the nutrient agar on which the nail-well was placed. To perform this test, we first prepared a soft Sabouraud dextrose agar [SDA, 30g Sabouraud Dextrose mix (DIFCO, Detroit, MI, USA) plus 4.5g agar in 1 litre of dH2O, with pH adjusted to 5.2 and autoclaved at 121oC for 20min]. When the soft SDA had cooled to 42oC, a liquid suspension of T. rubrum mycelial fragments was added and thoroughly mixed in the medium with a magnetic stir bar. The suspension was prepared by placing actively growing mycelia of T. rubrum from the surface of a regular SDA petri plate (identical to the soft SDA except that 18g of agar was added to 1 litre of medium instead of 4.5g) in sterile distilled water in a sterile blender (Waring Dynamics Corp., New Hartford, CT, USA) and blending for 30 sec. For each 100 ml soft SDA, 5 ml of the mycelial suspension was added, representing a final density of ~105 colony forming units per ml in the soft SDA medium. 2.2 ml of the soft SDA containing the T. rubrum mycelial fragments were then transferred to each sterile 4ml plastic cuvette. A leak-tested nail-well was then placed on top of the soft SDA agar in each cuvette and an appropriate treatment was added to the well (Figure 1B). In this experiment, two treatments with five replicates each were performed: 200µl Ringer’s Solution (per litre, 7.2g NaCl, 0.17g CaCl2, 0.37g KCl, pH 7.3) or 200µl BioCepta PM. Prepared cuvettes containing the inoculated soft SDA medium with a nail-well on top were covered tightly with parafilm and incubated at 30oC. A spectrophotometric reading of optical density at 600 nm was taken every 24hrs for 7 days through the agar to measure of the effect of permeated drugs on fungal growth. Un-inoculated SDA in 4 ml cuvettes was used as the spectrophotometric blank. Our results showed that none of cuvettes with un-inoculated SDA exhibited any change in OD600 reading, with all readings remaining between 0.000-0.002 (detailed data not shown) over the 7 days. In contrast, the inoculated SDA all showed noticeable fungal growth over the first two days. The cuvettes containing nail-wells filled with Ringer’s Solution showed continued fungal growth through all 7 days (Table 1). However, the BioCepta PM-treated cuvettes showed no further fungal growth from day 3 to day 7 (Table 1). The nail-well apparatus allowed us to clearly demonstrate penetration of the nail by the drug. Our results showed that BioCepta PM effectively penetrated the nail discs and inhibited the growth of T. rubrum in the medium by three days after initiating treatment.
Table 1. Evidence for drug permeation across the human nail in the nail-well and the drug’s inhibition of fungal growth in medium underneath the nail-well. Values in table are the mean + standard deviation of OD600 readings of five repeats.
Treatment |
Number of Day(s) Post Treatment (N=5 in each treatment) |
0 |
1 |
2 |
3 |
4 |
5 |
6 |
7 |
Ringer’s Solution |
0.029+0.003 |
0.042+0.006 |
0.099+0.004 |
0.125+0.005 |
0.141+0.008 |
0.156+0.006 |
0.164+0.005 |
0.188+0.004 |
BioCepta PM |
0.029+0.001 |
0.053+0.005 |
0.102+0.042 |
0.098+0.044 |
0.081+0.038 |
0.081+0.039 |
0.080+0.040 |
0.081+0.043 |
Effect of drug application on fungi embedded within the nail discs
In this experiment, we first infected the nail discs in the nail-wells with T. rubrum and then tested the effect of BioCepta PM on the fungus. To establish infection of the nail disc in the nail-well, we first established a vigorously growing lawn of T. rubrum on a large petri dish (15cm in diameter) containing SDA medium. This mycelial lawn was generated by inoculating 1 ml of a blended mycelial suspension of T. rubrum strain ATCC18759 and incubating at 30oC for 3 to 4 days. Nail-wells were leak-tested for one hour with 200µl of sterile dH2O to ensure no leakage. They were then placed on the T. rubrum lawn, with the ventral side of the nail directly on top of the fungal mycelia. The water used in the leak test was left in the nail-wells to help maintain humidity. The plates were incubated at 30oC for two weeks to allow full nail colonization by the fungus. After the nails were infected, the water in the wells was removed and the wells were dried with sterile cotton swabs.
The infected nail-wells were placed in 4 ml cuvettes and separated into two treatment groups, each with 6 repeats. The first treatment was 200µl sterile Ringer’s Solution in each of the six nail-wells and the second treatment was 200µl BioCepta PM in each nail-well (Figure 1C). Both treatments were applied for 8h daily for 7 days. At the end of each 8h application, sterile cotton swabs were used to absorb the liquid drug formulation and the nail-wells remained dry inside for the next 16h until the next application. Any permeated liquid was allowed to remain in the cuvettes, in contact with the nail disc in the nail-well. All nail-wells were placed in a 30oC incubator. At the end of these treatments, the nail discs were removed from the nail-wells. Permeated liquid was drained off the nail discs. Each nail disc was cut into two halves using a sterile steel blade. One half of each nail disc was plated onto a modified Dermatophyte Test Medium [DTM: SDA containing antibiotics (0.5g cycloheximide, 0.1g gentamicin, and 0.1g chloramphenicol), and 18.0g agar in 1 litre of dH2O; autoclaved at 121oC for 20min] and incubated at 30oC for two weeks. The other half of each nail disc was used to assay for the quantity of fungal cellular ATP using the ATP Bioluminescence Kit from Roche (Roche Diagnostics Canada, Laval, Quebec, Canada), following the manufacturer’s protocol.

Figure 1. Schematic diagrams showing nail-well construction and drug testing using the nail-well. (A) A cutaway view of nail-well construction using heat-shrink tubing. (B) The setup for testing drug permeation through the nail disc and its impact on fungal growth in the medium below. (C) A cutaway view of the nail-well containing the drug on top of the nail disc in the well and fungal infection from underneath the nail-well (i.e. ventral side of nails).
Our results showed that all 6 nail discs treated with the Ringer’s Solution had vigorous growth of T. rubrum on the modified DTM. In contrast, none of the 6 nail discs treated with seven 8h doses of BioCepta PM had growth of T. rubrum (Figure 2). The results indicated that within seven days, BioCepta PM effectively permeated throughout the nail discs and eliminated all live T. rubrum cells throughout the nails. The conclusion is also supported by data from the ATP Bioluminescence assay. Specifically, infected nails treated with seven 8h doses of BioCepta PM had 0.26% (N=6; standard deviation, +0.05%) of ATP Bioluminescence activity of those treated with Ringer’s Solution.

Figure 2. Growth of Trichophyton rubrum on the modified Dermatophyte Test Medium from infected nails after treatment with either the Ringer’s Solution (R) or BioCepta PM (F1) for seven treatments of 8h each. Six repeats were done for each of the two treatments and the plates were incubated at 30oC for two weeks. No growth of T. rubrum was observed in any of the six BioCepta PM-treated nails while growth was observed in all six Ringer’s Solution-treated nails.
In conclusion, we showed that nail-wells could be easily and inexpensively constructed. These nail-wells allowed us to test the permeation of a novel antifungal drug BioCepta PM and to determine its antifungal activity against the dominant agent of onychomycosis, T. rubrum, either embedded in the nail or in medium on the other side of the nail. Our results suggest that BioCepta PM has great potential for treating onychomycosis. Using these nail-wells, we were able to directly infect and treat the infected nails for subsequent analyses. In combination with spectrophotometry, ATP bioluminescence assay, and direct culturing of nail discs on dermatophyte test medium, these nail-wells allowed us to generate quantitative, statistically- analyzable data, with a range of treatments and sufficient replications for drug development testing, all at a relatively modest expense.
We thank Dr. Deborah Yamamura for the T. rubrum strain ATCC18759.
- Ghannoum MA, Hajjeh RA, Scher R, Konnikov N, Gupta AK, et al. (2000) A large-scale North American study of fungal isolates from nails: the frequency of onychomycosis, fungal distribution, and antifungal susceptibility patterns. J Am Acad Dermatol 43: 641–648. [Crossref]
- Ogasawara Y (2003) Prevalence and patient’s consciousness of tinea pedis and onychomycosis. Nihon Ishinkin Gakkai Zasshi 44: 253–260. [Crossref]
- Haneke E, Roseeuw D (1999) The scope of onychomycosis: epidemiology and clinical features. Int J Dermatol 38 Suppl 2: 7–12. [Crossref]
- Scher RK (1994) Onychomycosis is more than a cosmetic problem. Br J Dermatol 130: 15. [Crossref]
- Elewski BE (1998) Onychomycosis: pathogenesis, diagnosis, and management. Clin Microbiol Rev 11: 415–429. [Crossref]
- Seebacher C, Bouchara JP, Mignon B (2008) Updates on the epidemiology of dermatophyte infections. Mycopathologia 166: 335–352. [Crossref]
- Xu J, Yoell HJ (2012) Onychomycosis: an overview with a focus on diagnosis. Exp Lab Med 30: 111-118.
- Ghannoum M, Isham N (2014) Fungal Nail Infections (Onychomycosis): A Never-Ending Story? PLoS Pathog 10: e1004105. [Crossref]
- Khengar RH, Jones SA, Turner RB, Forbes B, Brown MB (2007) Nail swelling as a pre-formulation screen for the selection and optimisation of ungual penetration enhancers. Pharm Res 24: 2207-2212. [Crossref]
- Hui X, Shainhouse Z, Tanojo H, Anigbogu A, Markus GE, et al. (2002) Enhanced human nail drug delivery: Nail inner drug content assayed by new unique method. J Pharm Sci 19:189–195. [Crossref]